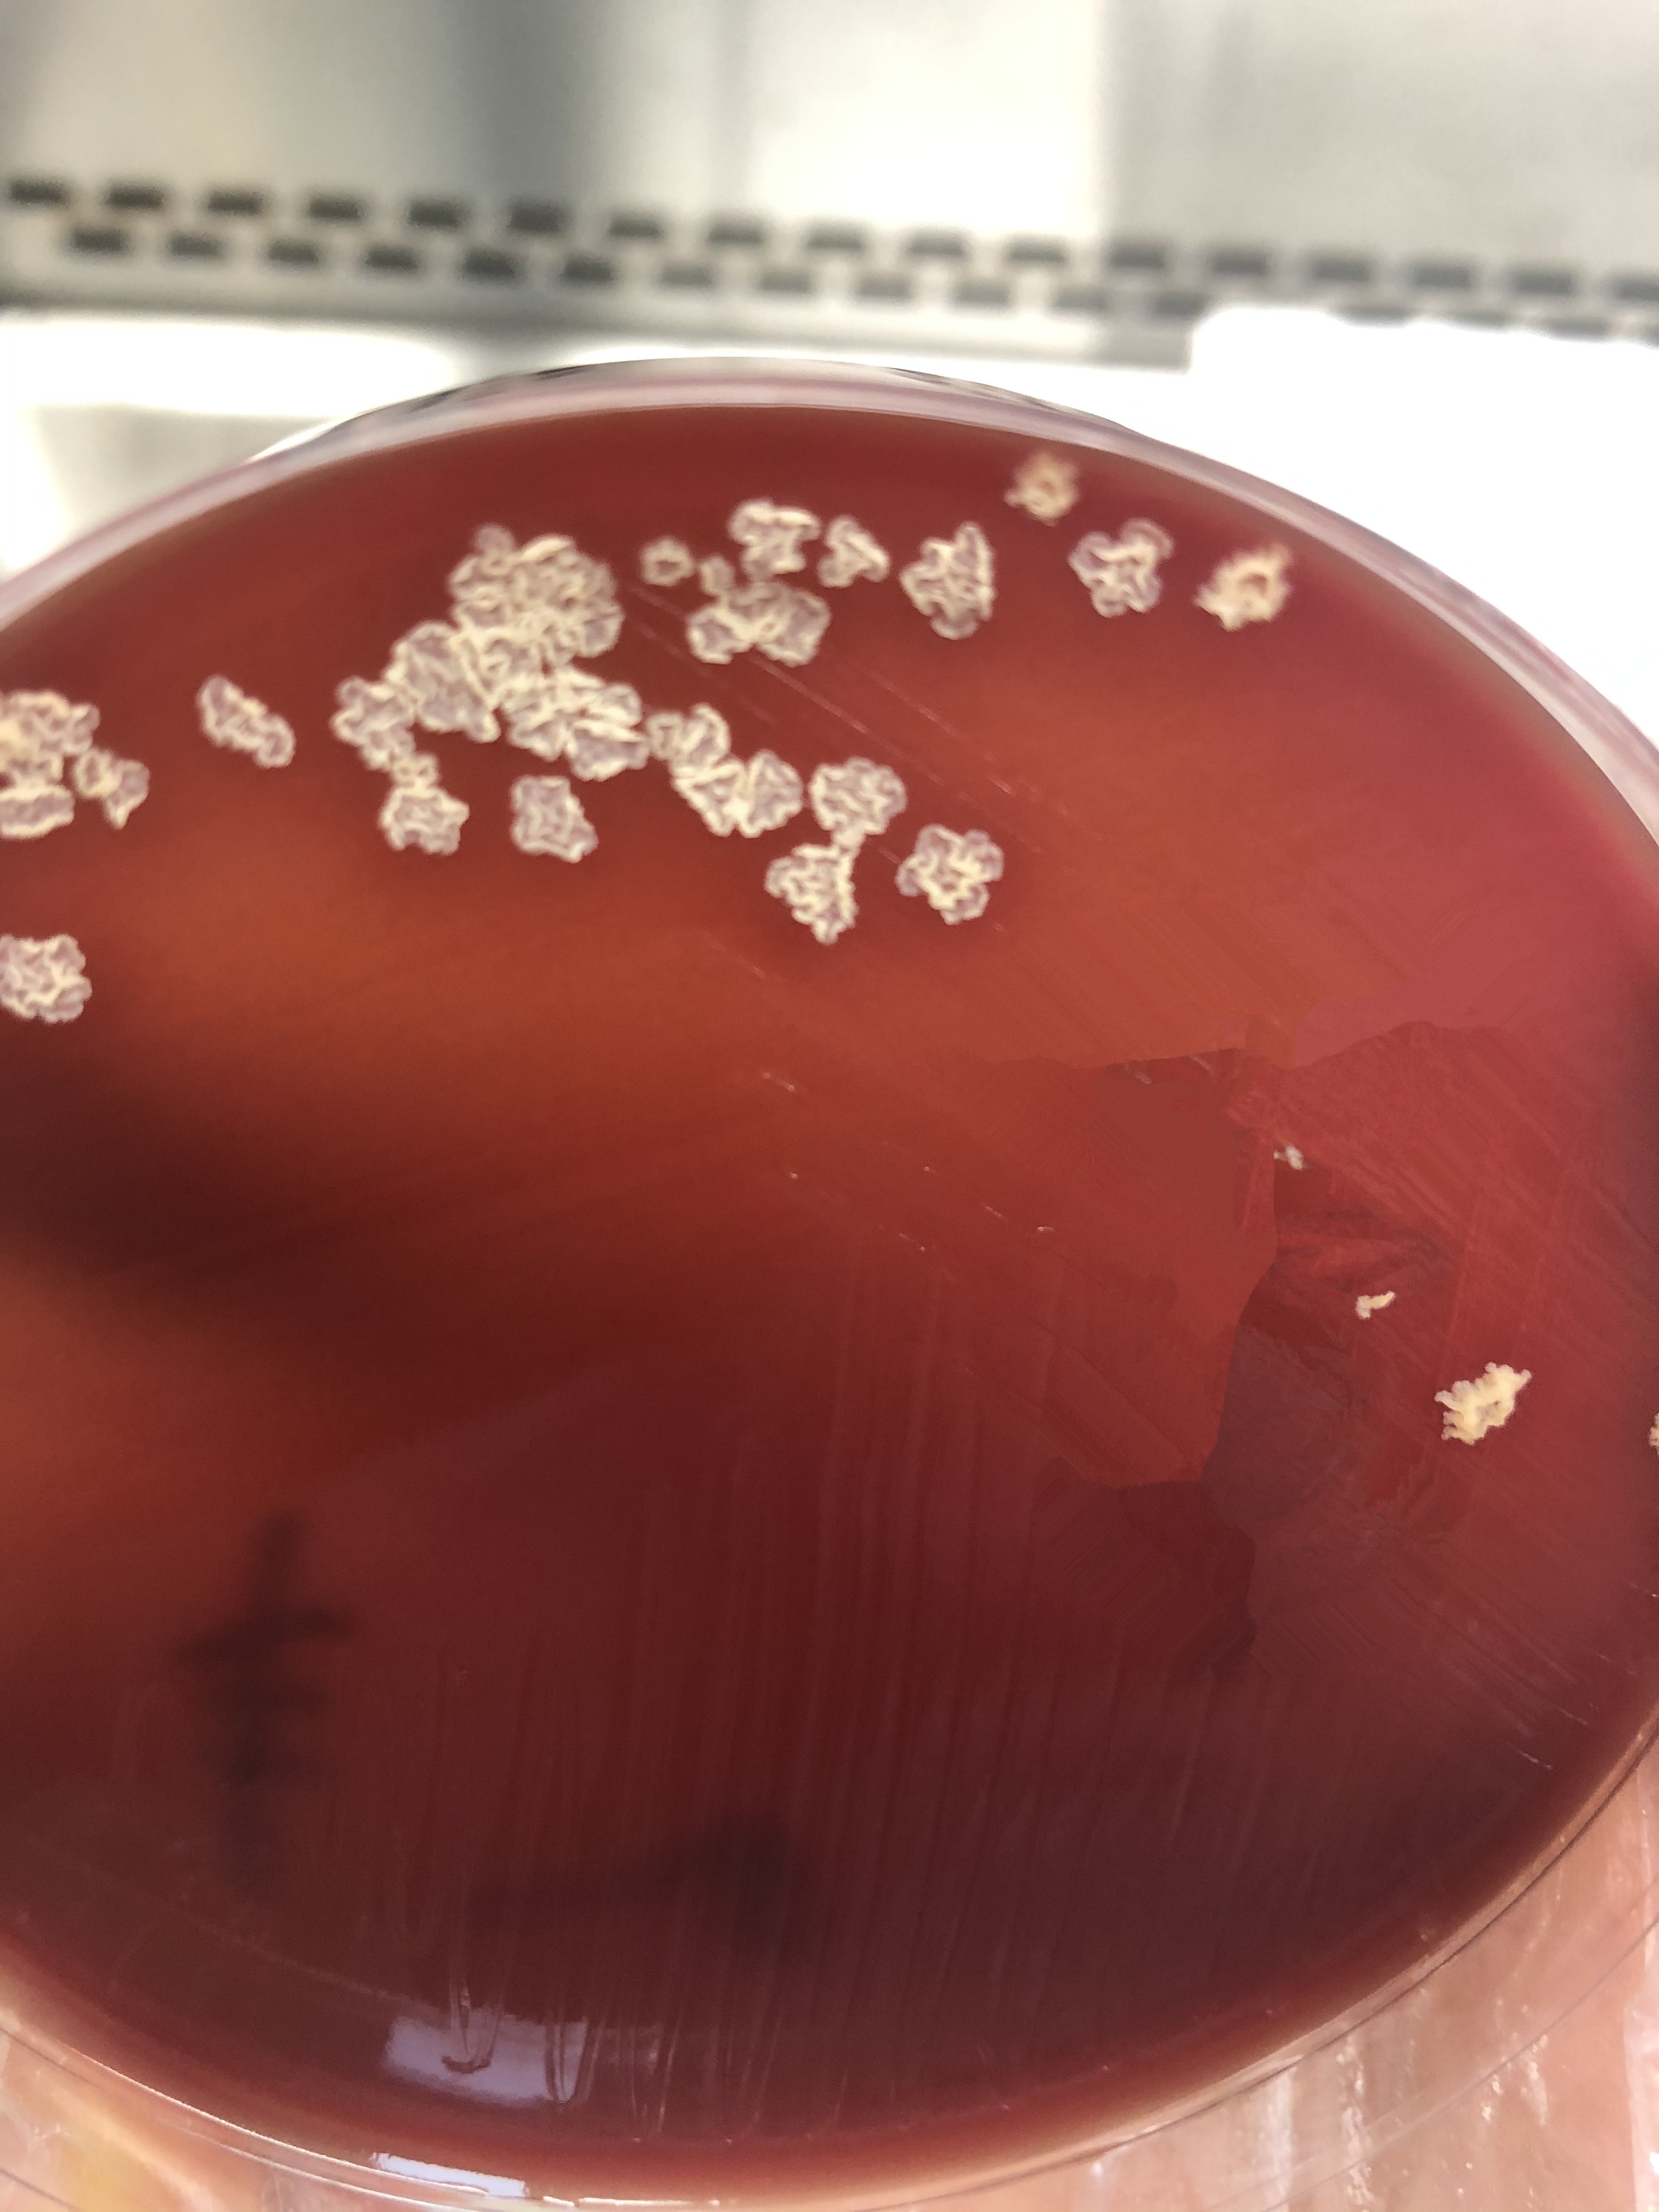

奴卡菌革兰染色呈分枝状

奴卡菌弱抗酸染色阳性
培养5天奴卡菌形态
近日,检验二科微生物室接到临床科室电话,有个患者肺部CT显示双肺多发弥漫满片状、结节状高密度影,边缘模糊,可见空洞,纵膈内见多发稍大淋巴结,考虑肺结核可能性大,希望加快对其痰标本的抗酸染色检查,以进一步确认。
检验二科微生物室组长刘唯加急将该患者痰标本予以革兰染色和抗酸染色处理,检见该患者痰标本抗酸染色为阴性,而革兰染色却发现许多着色不均的分枝菌丝,怀疑该患者并非肺结核,可能为奴卡菌感染。对他的痰标本予以弱抗酸染色处理,结果呈阳性。根据上述实验室检查情况,结合该患者的临床及影像学表现,刘唯组长向临床科室反馈考虑该病人为奴卡菌感染可能性大,临床科室据此加用了磺胺类抗生素对症施治,该患者4日后好转出院。
奴卡菌为放线菌目奴卡菌属,需氧革兰染色阳性杆菌,抗酸染色阴性或弱阳性,弱抗酸杆菌阳性。广泛分布于土壤、水、腐烂的动植物等,多数为非致病菌。检验二科陈键主任介绍奴卡菌感染多见于免疫缺陷或免疫力低下者,临床上可以引起人类皮肤、呼吸道、肾脏、肝脏等多处感染,其中以肺部感染最为多见,感染后其临床表现、影像学表现与常见细菌性肺炎相似,一般临床医生在对特殊肺炎的考虑多倾向于结核、真菌等,较少考虑奴卡菌。陈键主任提醒奴卡菌感染可选择多种抗菌药物治疗,传统推荐方案为磺胺类抗生素,治疗周期推荐6~12个月,如果在患者疾病早期能够正确认识,及早有效治疗,可有效改善预后,减少患者经济负担。(检验二科 肖曦 )